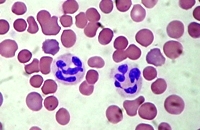
Leukociti

OSTALI SEMINARSKI RADOVI
IZ MEDICINE |
|||||||||||||||||||||||||||||||||||||||||||||||||||||||||||||||||||||||||||||||||||||||||||||||||||||||||||||||||||||||||||||||||||||||||||||||||||
|
|||||||||||||||||||||||||||||||||||||||||||||||||||||||||||||||||||||||||||||||||||||||||||||||||||||||||||||||||||||||||||||||||||||||||||||||||||
KRVNA SLIKA
 Krvna
slika je medicinski pojam s kojim se svakodnevno susreću brojni
pacijenti. Njihov odlazak u laboratorij radi vađenja i pregleda krvi,
osim straha od uboda, izaziva znatiželju te pacijenti redovito nastoje
što prije dobiti odgovor na pitanja koja ih muče: zbog čega su upućeni
na pretragu krvi, koja vrsta pretrage se traži, koje su normalne vrijednosti,
i ono najbitnije: što se može zaključiti ako postoji odstupanje od normalnih
vrijednosti?
Krvna
slika je medicinski pojam s kojim se svakodnevno susreću brojni
pacijenti. Njihov odlazak u laboratorij radi vađenja i pregleda krvi,
osim straha od uboda, izaziva znatiželju te pacijenti redovito nastoje
što prije dobiti odgovor na pitanja koja ih muče: zbog čega su upućeni
na pretragu krvi, koja vrsta pretrage se traži, koje su normalne vrijednosti,
i ono najbitnije: što se može zaključiti ako postoji odstupanje od normalnih
vrijednosti?
Podaci koji se dobiju pregledom krvi za većinu pacijenata su »tabula
rasa«, potpuna nepoznanica; oni su uglavnom, bez komentara, zadovoljavaju
se zaključkom i tumačenjem svoga liječnika. Manjina pokušava sama saznati
»pravu istinu« čitajući razne medicinske leksikone, udžbenike ili pak
traži objašnjenja od drugih liječnika, ne rijetko i od znanaca, medicinskih
laika, koji slove kao pravi stručnjaci u interpretaciji vrijednosti izraženih
u postocima, jedinicama, miligramima itd.
Još od davnih vremena ljudi povezuju krv sa zdravljem, bolešću i smrću.
U mnogih naroda, milijuni ljudi vjeruju da su bolesti posljedica pokvarene,
nečiste krvi. Zbog takvoga shvaćanja liječnici su stoljećima puštanje
krvi smatrali najvažnijom metodom liječenja. Ispuštanje »nečiste krvi«
pomoću kupica ili pijavica održalo se u narodnoj medicini do današnjeg
dana.
U nastojanju da se djeluje na količinu i sastav krvi, historija medicine
puna je primjera upotrebe ljudske i životinjske krvi u svrhu liječenja.
Neki su je pili, drugi su se u krvi prali i kupali, ili su je žrtvovali
svojim bogovima. Krv su smatrali sjedištem duše, nosiocem nasljednih osobina
(»Moja djeca, moja krv«). Još i danas postoje brojne zablude, npr.: da
je menstrualna krv otrovna, da se krv čisti preko gnojnih čireva, da se
pretragom krvi mogu ustanoviti gotovo sve bolesti itd.
Za liječnika je pregled krvi važno pomoćno sredstvo prilikom postavljanja
dijagnoze bolesti. Neke bolesti mogu se isključivo dokazati samo pretragom
krvi. To je potpuno shvatljivo ako uzmemo u obzir činjenicu da krv u svom
optoku dolazi u dodir sa svim dijelovima tijela. To je neophodno jer krv
omogućuje život stanicama tijela donoseći im kisik iz pluća te hranu iz
crijeva a obratnim putem odstranjuje iz tijela otpadne tvari koje stanice
izlučuju u krv.
Da bi udovoljila svim tim funkcijama, krv je neobično složeno sastavljena.
Sastoji se od krutoga i tekućeg dijela. Tekući dio krvi naziva se krvna
plazma i čini nešto malo više od polovine volumena krvi. U njoj su otopljene
razne tvari: minerali, hormoni, encimi, bjelančevine, šećer vitamini,
zatim razni otpadni produkti mijene tvari, kao masne kiseline, aminokiseline,
mokraćevina, amonijak, kreatin, žučne boje itd. Slani okus krvi potječe
od otopljene kuhinjske soli. U krvi se nalaze i zaštitne tvari (antitijela)
protiv raznih bolesti. Količinu, sastav, te aktivnost većine tih supstancija
danas se može odrediti laboratorijskim pretragama.
Crvena krvna slika
Određivanje »crvene krvne slike« jedna je od najčešćih pretraga krvi. Crvena krvna slika naziva se zbog toga što se tom pretragom ustanovljuju vrijednosti onih krvnih elemenata koji svojom crvenom bojom daju karakterističnu boju krvi. To je i određivanje broja i oblika crvenih krvnih zrnaca te količina hemoglobina.
Eritrociti :
 Osnovna
uloga crvenih krvnih zrnaca je izmjena plinova u organizmu. Svojim
glavnim sastojkom hemoglobinom, eritrocit u plućima veže kisik koji donosi
tkivima: u obratnom smjeru prenosi ugljični dioksid koji se izdiše plućima.
Osnovna
uloga crvenih krvnih zrnaca je izmjena plinova u organizmu. Svojim
glavnim sastojkom hemoglobinom, eritrocit u plućima veže kisik koji donosi
tkivima: u obratnom smjeru prenosi ugljični dioksid koji se izdiše plućima.
Eritrociti su najbrojnije krvne stanice. Prema internacionalnoj statistici,
njihov broj u 1 kubičnom milimetru (ccm) iznosi između 4 i 5 milijuna.
Donja granica za muškarce je 4.500.000,
za žene 4.200,000. Beznačajne
varijacije u njihovu broju postoje u toku dana i noći.
Eritrociti su okrugle pločice promjera svega 7 tisućinki milimetara. U
sredini su udubljeni te u prosjeku izgledaju poput piškota. Prosječno
žive oko 100 dana. Normalno postoji ravnoteža između onih koji se raspadaju
i onih koji se stvaraju, jer njihov broj (uvijek mora biti toliko da osigurava
dovoljno dopremu kisika stanicama tijela).
U vezi s brojem i oblikom crvenih krvnih zrnaca često se susreću slijedeći
medicinski pojmovi:
mikrocitoza - prosječan promjer eritrocita je smanjen;
obično kod anemije uzrokovane manjkom željeza;
makrocitoza - promjer eritrocita je veći od normale;
kod posebnoga oblika slabokrvnosti nazvane perniciozna anemija;
hipokromija - eritrociti sadrže manje hemoglobina nego
što je normalno;
anizocitoza - eritrociti su nejednake veličine i mogu
se vidjeti kod raznih oblika slabokrvnosti;
retikulocitoza - pojava retikulocita u krvi. To su nezreli
eritrociti i u krvi se pojave onda kada koštana srž stvara eritrocite
velikom brzinom, te mnogi dospiju u perifernu krv prije nego što sazru.
Osim u nekih bolesti, javlja se kao normalna pojava nakon gubitka veće
količine krvi;
anemija - stanje kada
pad broja eritrocita i smanjena količina hemoglobina umanjuje sposobnost
krvi da prenosi kisik. Simptomi koji se javljaju ovise prvenstveno o jačini,
stupnju anemije, a ne o njenoj vrsti. Javljaju se slijedeći znakovi: umor,
klonulost, omaglica, vrtoglavica, nesvjestica, gubitak apetita, trnci,
mravinjanje, žmarci u prstima ruku i nogu, smetnje gutanja itd.
Hemoglobin:
 Krvna
boja hemoglobina glavni je sastojak crvenoga krvnog zrnca; eritrocit
čini sposobnim za prijenos kisika; također sudjeluje u transportu ugljičnoga
dioksida iz tkiva u pluća. Hemoglobin (Hb) ima važnu ulogu u održavanju
slabo lužnate reakcije krvi. Kada se u krvi pojave kiseli produkti mijene
tvari, hemoglobin, s još nekim kemijskim spojevima koji se nalaze u krvi,
sudjeluje u njihovom poništavanju (neutralizaciji).
Krvna
boja hemoglobina glavni je sastojak crvenoga krvnog zrnca; eritrocit
čini sposobnim za prijenos kisika; također sudjeluje u transportu ugljičnoga
dioksida iz tkiva u pluća. Hemoglobin (Hb) ima važnu ulogu u održavanju
slabo lužnate reakcije krvi. Kada se u krvi pojave kiseli produkti mijene
tvari, hemoglobin, s još nekim kemijskim spojevima koji se nalaze u krvi,
sudjeluje u njihovom poništavanju (neutralizaciji).
Normalne vrijednosti hemoglobina: 14 do
16 grama na 100 kubičnih
centimetara krvi.
Bitni sastavni dio hemoglobina je željezo. U tijelu ima
ukupno oko 4 grama željeza, a više od polovine nalazi se u hemoglobinu.
Željezo se neprekidno, u manjim količinama (0,6 mg dnevno), gubi stolicom,
pa je razumljivo da količina mora biti nadoknađena željezom u hrani. Dnevna
potreba za željezom je različita. U žena je potreba za željezom veća jer
se menstruacijom povećava gubitak željeza iz organizma čak više od 2 mg
dnevno. I u trudnoći postoji povećana potreba žene za željezom, jer dojenče
dolazi na svijet s rezervom željeza koju dobiva od majke. Također je razumljiva
povećana potreba organizma za željezom nakon većega gubitka krvi (razna
krvarenja).
Nedovoljna količina željeza najčešći je uzrok slabokrvnosti (anemije).
Javlja se češće u žena za vrijeme trudnoće, dojenja ili menstruacije.
Javlja se također u osoba koje imaju smanjenu količinu želučane kiseline,
koja je potrebna radi upijanja željeza u krv.
Osim općih znakova anemije, javlja se upala jezika, smetnje gutanja
i promjena na noktima, koji postaju krhki, suhi, udubljeni te često puni
sitnih bjeličastih mrlja.
Mnogo željeza ima povrće, žumanjak jajeta, meso, iznutrice. Željezo
se može primati u obliku tableta, tekućina te putem injekcija. Koji put
je potrebna transfuzija krvi.
Indeks boje:
Služi kao gruba orijentacija u odnosu količine hemoglobina u promatranom
eritrocitu prema količini hemoglobina u normalnom eritrocitu. Određuje
se pomoću posebnog aparata - hemog-lobinometra. Normalna vrijednost
indeksa boje je 1 (tolerantna
vrijednost od 0,9 - 1,1).
Ako je indeks boje manje od 1, riječ je o smanjenoj količini hemoglobina
u krvi. Uglavnom su to anemije zbog pomanjkanja željeza. Ako je indeks
boje veći od 1, znači da se broj eritrocita smanjio više nego što se smanjila
količina hemoglobina. Indeks boje može biti 1 i kod slabokrvnosti, što
znači da se istovremeno i jednakomjerno smanjuje broj crvenih krvnih zrnaca
i količina hemoglobina.
Bijela krvna slika
Bijelom krvnom slikom određuju se broj, oblici i vrste bijelih
krvnih zrnca - leukocita. Leukociti se stvaraju u leđnoj moždini
i limfnim čvorovima. Njihova zadaća je odbrana organizma od različitih
vrsta mikroorganizma. To su pokretne krvne stanice i njihov transport
je uvijek usmjeren u područje prodora bakterija
(upala).
Broj
leukocita u perifernoj krvi normalno iznosi između 4
000 do 10 000 u 1 cmm. Povišenje broja leukocita iznad
10 000 naziva se leukocitoza, a smanjenje ispod 4 000 naziva
se leukopenia. Leukociti se označavaju velikim slovom L.
Broj
leukocita u perifernoj krvi normalno iznosi između 4
000 do 10 000 u 1 cmm. Povišenje broja leukocita iznad
10 000 naziva se leukocitoza, a smanjenje ispod 4 000 naziva
se leukopenia. Leukociti se označavaju velikim slovom L.
Povećanje broja leukocita je nespecifična reakcija organizma i nastaje
kod najvećeg broja raznih bakterijskih infekcija, no javlja se i kod nekih
gljivičnih, parazitnih i rijetkih infekcija. Njihovo povećanje popratna
je pojava prilikom otrovanja, tumora i alergičnih reakcija. Prema tome,
povećan broj bijelih krvnih zrnaca ukazuje liječniku samo na činjenicu
da se u organizmu zbivaju neke, najčešće upale, promjene.
Leukopenija označava pad broja leukocita ispod 4 000 u 1 cmm.
U rijetkim slučajevima postoje i zdrave osobe koje imaju stalno smanjen
broj leukocita. Smanjenje broja bijelih krvnih zrnaca može izazvati izlaganje
hladnoći, loša prehrana te neke zarazne bolesti, npr. trbušni tifus, gripa,
zarazna žutica, malarija. Najčešće je riječ o smanjenom broju tzv. neutrofilnih
leukocita. Njihovo smanjenje nastaje i djelovanjem štetnih tvari na koštanu
srž, u kojoj se leukociti stvaraju. Tako će leukopenija nastati prilikom
otrovanja živom, benzolom, nekim lijekovima te radioaktivnim zračenjem.
Kada u potpunosti prestane proizvodnja bijelih krvnih zrnaca -zbog oštećenja
koštane srži - nastaje stanje koje se naziva agranulocitoza.
S obzirom na to da u organizmu postoje brojne bakterije koje žive u ravnoteži
s obrambenim snagama organizma, prestanak stvaranja bijelih krvnih tjelešaca
dovodi do njihova razmnožavanja i do različitih infekcija koje su upravo
karakteristične za takvo stanje.
Za liječnika nije značajan samo ukupan broj bijelih krvnih zrnaca, često
je važniji nalaz broja i međusobnoga odnosa između pojedinih vrsta bijelih
krvnih zrnaca. Taj odnos određuje se tzv. diferencijalnom krvnom slikom
(DKS).
U normalnoj krvi postoji 5 vrsta bijelih krvnih zrnaca.
Od 100 izbrojenih leukocita prosječni odnos je slijedeći:
Neutrofilni leukociti 60 - 70%
Eozinofilni leukociti 1-4 %
Bazofilni leukociti 0-1 %
Monociti 4 do 8 %
Limfociti 23 do 35%
Neutrofilni leukociti uglavnom su povećani u apsolutnom a ne samo relativnom
odnosu na druge vrste bijelih krvnih zrnaca. Povećanje broja neutrofilnih
leukocita (neutrofilija) najčešće se kreće od 15 000 do 30 000, rijetko
do 100 000. Najčešći su uzrok povećanja njihova broja bakterijske
infekcije, osim nekih bolesti kao što su npr. tuberkuloza,
trbušni tufus, bruceloza. Neutrofilija će se također javiti prilikom raznih
otrovanja, naročito onih koja dovode do razaranja tkiva u organizmu. Neutrofiliju
mogu izazvati i neke zarazne bolesti npr. srčani
infarkt, ciroza jetre, tumori.
Povećani broj neutrofilnih leukocita može se javiti prilikom težega mišićnog
rada, no u takvim slučajevima njihov se broj vraća na normalu za otprilike
1 sat.
Smanjenje broja neutrofilnih leukocita naziva se neutropenia. Eozinofilija
je stanje povećanoga broja eozinofilnih leukocita. Njihov
postotak u bijeloj krvnoj slici tada iznosi više od 4%. Najčešći uzrok
porasta broja eozinofila su parazitarne infestacije i pasja glista, svinjska
glista, bijela dječja glista itd. Blaži porast broja eozinofila uzrokuju
i alergične bolesti, np. bronhijalna astma,
urtikarija itd. Može se javiti kod zaraznih bolesti (šarlah) i tumora.
Smanjenje broja eozinofilnih leukocita naziva se eozinopenija (kod većine
akutnih bakterijskih infekcija).
Bazofilija je vrlo rijetka pojava. Broj bazofilnih leukocita je malen,
te se najčešće ne nalaze u diferencijalnoj krvnoj slici. Smatra se da
ti leukociti luče heparin, supstanciju koja sprečava grušanje krvi. Njihov
broj je umjereno povećan kod nekih rijetkih bolesti.
Limfocitoza najčešće označava samo relativno povećanje broja limfocita
u odnosu prema drugim vrstama bijelih krvnih zrnaca, pretežno neutrofila.
Apsolutno povećanje limfocita mnogo je rjeđa pojava koja se normalno može
javiti u dječje doba. Od bolesti najčešće se javlja kod velikog kašlja
(pertusis) i još nekih bolesti izazvanih bacilima. Postoje i
dvije virusne infekcije koje karakterizira povećan broj limfocita; to
su infektivna limfocitoza i infektivna mononukleoza.
Limfociti su najznačajnije stanice imunološkoga
obrambenog sustava; odgovorni su za stvaranje specifičnih obrambenih
tjelešaca tzv. antitijela. Limfociti su zapravo skupina različitih stanica
koje se međusobno razlikuju ne samo po funkciji nego i dužini života.
Povećan broj monocita naziva se monocitoza; javlja se kod nekih bolesti
kao što su bakterijska upala srčanih zalistaka, zarazna žutica, neki oblici
tuberkuloze, malarija itd.
Sedimentacija
 Crvena
krvna zrnca, ako je spriječeno zgrušavanje krvi, talože se postepeno na
dno posude. Kod nekih bolesti dolazi do izvjesnih promjena u crvenim krvnim
zrncima i krvnoj plazmi, zbog kojih se ta zrnca skupljaju u manje ili
veće grupe; zbog toga je taloženje eritrocita ubrzano. Liječnici su to
davno uočili, ali kao dijagnostičku metodu primijenili su prvi put tek
početkom ovog stoljeća.
Crvena
krvna zrnca, ako je spriječeno zgrušavanje krvi, talože se postepeno na
dno posude. Kod nekih bolesti dolazi do izvjesnih promjena u crvenim krvnim
zrncima i krvnoj plazmi, zbog kojih se ta zrnca skupljaju u manje ili
veće grupe; zbog toga je taloženje eritrocita ubrzano. Liječnici su to
davno uočili, ali kao dijagnostičku metodu primijenili su prvi put tek
početkom ovog stoljeća.
Za određivanje brzine sedimentacije vadi se 2 ccm krvi iz vene,
uz dodatak supstancije koja sprečava zgrušavanje krvi. Krv se usiše u
specijalnu baždarenu epruvetu i taloženje eritrocita očitava se nakon
prvoga i drugoga sata. Postoji više metoda za određivanje brzine sedimentacije
(SE), u našoj je zemlji uobičajena metoda po Westergrenu. Normalna
je sedimentacija eritrocita manja od 15
mm za 1 sat, najčešće je 3 do 5 milimetara nakon prvoga
sata 7 do 15 mm nakon drugoga. Normalna je pojava ubrzana sedimentacria
za vrijeme trudnoće, menstruacije te u starijih osoba.
Pravi uzrok ubrzane sedimentacije još nije u potpunosti razjašnjen. Smatra
se da kod nekih bolesti u krvi nastaju specifične bjelančevine koje su
glavni uzrok ubrzanja. Naročito se javljaju kod onih bolesti kada dolazi
do raspadanja tkiva i prodora raspadnutih tvari u krv,
npr. prilikom akutnoga srčanog infarkta,
tuberkuloze, reumatoidnoga artritisa,
reumatske groznice itd. Ubrzana sedimentacija nastaje kod većine akutnih
i kroničnih zaraznih bolesti i mnogih otrovanja.
Tumori izazivaju ubrzanu sedimentaciju jedino onda ako
su skloni raspadanju ili ako izazivaju upalnu reakciju u okolini.
Određivanjem brzine sedimentacije ne može se postaviti dijagnoza bolesti,
slično, kao što se ne može postaviti dijagnoza bolesti određivanjem visine
tjelesne temperature ili određivanjem broja bijelih krvnih zrnaca. Sedimentacija
eritrocita je nespecifična reakcija organizma i javlja se ubrzana kod
velikog broja zaraznih bolesti. Ubrzana sedimentacija ukazuje liječniku
samo na činjenicu da se u organizmu zbivaju nenormalne promjene. Liječnik
će tada drugim dijagnostičkim postupcima tragati za mjestom i uzrokom
bolesti. Prema tome, određivanje brzine sedimentacije samo je pomoćna
dijagnostička metoda.
Praćenje brzine sedimentacije u toku bolesti ima važno prognostičko značenje.
Smanjenje brzine sedimentacije u mnogih bolesti znak je smirivanja
bolesnoga procesa, dok njeno ubrzanje znači napredovanje bolesti ili komplikacije.
Ubrzana sedimentacija može ukazati, kao prvi znak, na
skrivenu bolest dok ostali simptomi još ne postoje.
Trombociti
 Trombociti,
ili krvne pločice, imaju važnu ulogu u procesu grušanja
krvi i zaustavljanju krvarenja nastalih manjim oštećenjem stijenke krvne
žile; brojni se trombociti slijepe i kao čep zatvore pukotinu na krvnoj
žili.
Trombociti,
ili krvne pločice, imaju važnu ulogu u procesu grušanja
krvi i zaustavljanju krvarenja nastalih manjim oštećenjem stijenke krvne
žile; brojni se trombociti slijepe i kao čep zatvore pukotinu na krvnoj
žili.
Trombociti su najmanje krvne stanice. Njihov broj iznosi između 150
000 do 400 000 u kubičnom milimetru krvi. Do krvarenja
uglavnom dolazi ako broj trombocita padne ispod 70 000, no ne postoji
stalan i određen odnos između broja trombocita i sklonosti krvarenju.
Do smanjenja broja trombocita (trombocitopenija) dolazi u prvom
i drugom danu menstruacije, za vrijeme trudnoće i u početku infekcija.
Izrazitiji pad trombocita može biti posljedica alergije, naročito na neke
lijekove. Javlja se u toku bolesti kao što su uremija, šećerna
bolest. Postoji i tzv. idiopatska trombocitopenija, bolest
nepoznatoga uzroka, praćena krvarenjima u kožu i druga tkiva; postoje
i nasljedne, familijarne trombocitopenije.
Povećan broj trombocita (trombocitoza) viđa se kao prolazna pojava
kod nekih zaraznih i nezaraznih bolesti. Često se javlja u osoba kojima
je izvađena slezena te nakon obilnijega gubitka krvi.
preuzmi
seminarski rad u wordu » » »

